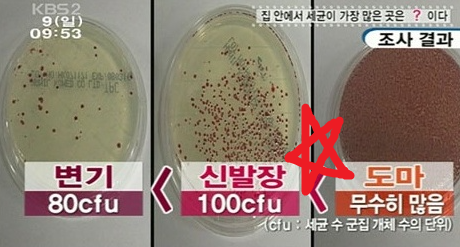

요리하는 것이 취미이신 분들이라면 한 번쯤은 생각해보셨을 거라고 생각합니다.
"식재료가 직접 닿는 도마는 과연 깨끗할까?"
저도 집에서 음식을 만들어 먹는 것을 좋아하지만,
"고기나 생선을 자르는 도마는 야채를 손질할 때 사용하면 안 된다" 정도의 상식만 갖고 있을 뿐,
매일 사용하는 도마가 얼마나 위생적인지에 대해서는 잘 모르고 있었습니다.
하지만 아니나 다를까..

매번 식재료를 손질할 때 사용하는 도마에 생긴 칼집에는
상상하지 못할 정도로 많은 세균 및 박테리아가 서식하고 있었습니다.
위와 같은 정보를 접하고 집에서 흔히 사용하는 도마가 생각보다 매우 비위생적이라는 것을 깨달은 후부터,
칼집이 나지 않는 도마를 사용해야겠다고 결심을 하게 됐습니다.
이와 관련된 제품을 찾던 도중,
제이엠그린이라는 기업으로부터 칼집 안나는 도마인 TPU도마를 협찬받게 되어 이렇게 제품 리뷰를 남기게 됐습니다.

이 도마의 정식 명칭은 더블세이브 TPU도마입니다.
(지금 보니 포장지 윗부분에 대통령 표창을 받은 기업이라고 적혀있네요.)
포장을 뜯어보도록 하겠습니다.

제가 협찬받은 칼집 안나는 도마인 TPU도마입니다.
총 세 가지 색상의 도마로 구성되어 있습니다.

조금 뜬금없긴 하지만,
여기서 TPU라는 소재가 무슨 소재인지 궁금하실 거라고 생각합니다.
TPU란, 고무의 탄성을 가진 플라스틱으로,
"높은 열을 가하지 않는 한,
다른 소재에 비해 물리적인 변형이 훨씬 덜한 고급 소재"
라고 보시면 됩니다.
또한 TPU도마는 다른 플라스틱 제품과 다르게 모양을 잡을 때 다른 화학약품을 사용하지 않아 친환경적이라고 합니다.
출처 : N지식백과
이러한 특성 때문에 TPU도마가 칼집 안나는 도마로 불리게 됐다고 보시면 될 것 같습니다.

칼집 안나는 TPU도마는 총 세 가지 색상으로 이루어져 있습니다.
회색은 생선용, 분홍색은 육류용, 초록색은 채소 및 과일용입니다.
그럼 바로 뜯어서 요리를 하는 데 사용해보도록 하겠습니다.


저는 이날 제육볶음을 만들었는데,
가장 먼저 마늘을 다지는데 칼집 안나는 도마인 TPU도마를 사용했습니다.

음..
생각해보니 마늘을 다지는 데에는 칼날이 필요하지 않아서 여기서는 칼집에 대한 부분을 설명드리지 못하겠네요.
그래도 더블세이브 TPU도마가 가볍고 바닥에 잘 밀착되다 보니 마늘을 다지는데도 도마가 움직이지 않아서 좋았습니다.


다음으로는 대파를 손질하는데 TPU도마를 사용했습니다.
도마가 생각보다 얇아서 정말 칼집이 안 나나 의아했지만,
정말 안나더군요.
다음으로는 돼지고기 앞다리살을 손질해보도록 하겠습니다.
어떻게 보면 이 부분이 칼집 안나는 TPU도마의 하이라이트라고 볼 수 있습니다.

손질된 고기를 샀으면 좋았겠지만,
노브랜드에 남은 앞다리살이 모두 통으로 된 것밖에 없어서 할 수 없이 이걸 구매했습니다.

열심히 앞다리살을 잘라줍니다.

보기만 해도 칼집이 생길 것 같은 기분이 듭니다.
하지만,

신기하게도 TPU도마에 칼집이 나지 않았습니다.
물론 작정하고 날카로운 칼로 마구 TPU도마를 썰면 칼집이 나긴 하겠지만,
확실히 다른 일반 도마에 비해서 칼집이 훨씬 덜 나는 것 같습니다.

그렇게 열심히 손질한 재료를 30분간 숙성시킨 뒤,
센 불에 제육볶음을 익혀줬습니다.
그 후,

맛있게 먹어주었습니다.
꿀맛입니다.
그럼 밑에서 칼집 안나는 도마인 TPU도마에 대한 총평을 말씀드리고 글을 마무리해보도록 하겠습니다.
총평
지금까지 칼집 안나는 도마 : TPU도마 리뷰를 해봤습니다.
TPU도마에 대한 사용 후기를 한 줄로 요약해서 말씀드리면,
"생각보다 매우 얇고 가볍지만, 칼집이 안 나서 신기했다."
정도로 볼 수 있을 것 같습니다.

또한 식재료를 일정한 크기로 자를 때 필요한 눈금 기능도 TPU도마에 내재되어 있습니다.
사실 이 기능이 없어도 도마의 기능은 충분히 하겠지만,
예쁜 음식 사진을 남기기 위해 플레이팅이 중요한 요즘 시대에 있으면 좋을 것 같은 기능이라는 생각이 듭니다.

[신제품] 더블세이브 TPU도마 3개 / 어디서든 간편하고 깔끔하게 : 제이엠그린 (naver.com)
[신제품] 더블세이브 TPU도마 3개 / 어디서든 간편하고 깔끔하게 : 제이엠그린
[제이엠그린] 국민이유식용기 알알이쏙, 이유식용기, 냉동용기, 밀폐용기, 아이디어 제품
smartstore.naver.com
칼집 안나는 TPU도마에 대한 세부적인 사항은 위의 링크를 참고해주세요!!
그럼 지금까지 칼집 안나는 TPU도마 : 더블세이브 리뷰였습니다.

감사합니다.
'일상 아이템 리뷰' 카테고리의 다른 글
| 초간단 소고기 미역국 끓이는 법 (0) | 2021.06.15 |
|---|---|
| 블루투스 리모컨 릿제로X 리뷰 (1) | 2021.06.08 |
| 에어팟 2세대 가죽 케이스 리뷰 (0) | 2021.06.04 |
| 사무용 의자 추천 : 생활지음 아이비 체어 (1) | 2021.05.28 |
| 마스크 입냄새 줄여주는 항균 구리 필터 마스크 (0) | 2021.05.27 |